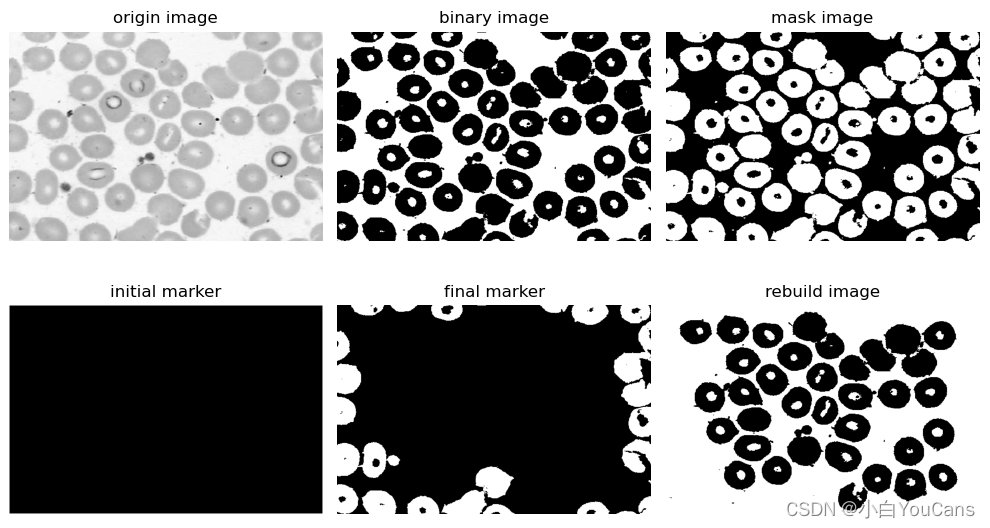
在这里插入图片描述

欢迎关注 『youcans 的 OpenCV 例程 200 篇』 系列,持续更新中
欢迎关注 『youcans 的 OpenCV学习课』 系列,持续更新中
【youcans 的 OpenCV 例程200篇】134. 形态学重建之细胞计数
4. 形态学图像重建
形态学重建的核心是测地膨胀和测地腐蚀。
图像的形态学重建涉及两幅图像和一个结构元:图像 F 是标记,包含重建的起点;图像 G 是模板,用来约束重建;结构元 B 定义连通性,通常是全 1 的 3*3 陈列。
在二值图像中,测地腐蚀或测地膨胀是将腐蚀或膨胀结果与模板图像 G 进行交集运算(与)或并集运算(或),在灰度图像中的推广则是以求最大值、最小值来取代二值的与或操作。
简单地说,测地膨胀和测地腐蚀就是有条件的膨胀和腐蚀。膨胀或腐蚀结果与模板图像进行交集或并集运算,从而对膨胀或腐蚀操作施加了特定的约束。
4.4 形态学边界清除
从图像中提取目标是图像处理的基本任务,检测接触边界是常用的算法。
对于二值图像 I(x,y)I(x,y)I(x,y),开发一种基于形态学重建的边界清除的算法:
使用原图像 III 作为模板,构造一幅标记图像 F。
标记图像 F 的边框位置为 III,其它位置均为 0(白色),即:
F(x,y)={I(x,y),(x,y)在边界上0,其它F(x,y) = \begin{cases} I(x,y) &, (x,y)在边界上\\0 &, 其它\end{cases} F(x,y)={I(x,y)0,(x,y)在边界上,其它
计算形态学重建 RID(F)R^D_I(F)RID(F) 提取接触边界的目标,由 X=I−RID(F)X= I - R^D_I(F)X=I−RID(F) 即可得到一幅由图像 I(x,y)I(x,y)I(x,y) 重建的,目标不接触边界的图像 X。
基于形态学重建的边界清除,首先构造标记图像 F。使用原图像 III 作为与操作的掩模模板,可以保护迭代期间所有的前景像素不会被改变。
标记图像 F 的边界为 I(x,y)I(x,y)I(x,y),属于接触边界的目标。除原图像中接触边界的目标之外,黑色从边界开始向内不断膨胀,直到充满图像。对收敛的标记图像求补,得到边界清除的重建结果。
例程 10.24:基于形态学重建的细胞计数
本例是基于形态学重建的细胞计数,需要清除边界上不完整的细胞,因此算法原理与边界清除是相同的。由于原图像是浅色背景,二值化处理后的背景为白色,因此用原图像的补集作为模板。
(1)构造标记图像 F 作为膨胀重建的标记,标记图像的边框位置为 III,其它位置均为 1;
(2)使用十字形结构元(MORPH_CROSS),对标记图像 F 进行膨胀恢复;
(3)用原图像的补集作为模板来约束重建,与膨胀恢复图像进行逻辑与;
(4)重复图像 F 的重构运算,直到达到稳定收敛状态;
(5)原图像(白色背景)与收敛的标记图像 F 或运算,得到边界清除的重建结果。
# 10.24: 基于形态学重建的细胞计数imgGray = cv2.imread("../images/imgBloodCell.png", flags=0) # flags=0 灰度图像ret, imgBin = cv2.threshold(imgGray, 205, 255, cv2.THRESH_BINARY) # 二值化处理 (黑色0/白色1)imgMask = cv2.bitwise_not(imgBin) # 二值图像的补集# 构造标记图像marker = np.zeros_like(imgBin, dtype=np.uint8)marker[0, :] = imgBin[0, :]marker[-1, :] = imgBin[-1, :]marker[:, 0] = imgBin[:, 0]marker[:, -1] = imgBin[:, -1]markerIni = marker.copy() # 标记图像: 边框 f(x,y)=I(x,y),其它为 0# 形态学重建element = cv2.getStructuringElement(cv2.MORPH_CROSS, (3, 3))while True:marker_pre = marker # 保存 F(n-1)dilation = cv2.dilate(marker, kernel=element) # 膨胀重建marker = cv2.bitwise_and(dilation, imgMask) # 原图像作为模板用来约束重建,按位与,有 0 得 0if (marker_pre == marker).all(): # F(n)=F(n-1)?,判断是否达到稳定收敛状态break# imgRebuild = imgBin + marker # 按位或,有 1 得 1imgRebuild = cv2.bitwise_or(imgBin, marker) # 按位或,有 1 得 1# 显示plt.figure(figsize=(10, 6))plt.subplot(231), plt.imshow(imgGray, cmap='gray'), plt.title("origin image"), plt.axis("off")plt.subplot(232), plt.imshow(imgBin, cmap='gray'), plt.title("binary image"), plt.axis("off")plt.subplot(233), plt.imshow(imgMask, cmap='gray'), plt.title("mask image"), plt.axis("off")plt.subplot(234), plt.imshow(markerIni, cmap='gray'), plt.title("initial marker"), plt.axis("off")plt.subplot(235), plt.imshow(marker, cmap='gray'), plt.title("final marker"), plt.axis("off")plt.subplot(236), plt.imshow(imgRebuild, cmap='gray'), plt.title("rebuild image"), plt.axis("off")plt.tight_layout()plt.show()
(本节完)
版权声明:
youcans@xupt 原创作品,转载必须标注原文链接:(https://blog.csdn.net/youcans/article/details/123527091)
Copyright 2022 youcans, XUPT
Crated:2022-3-18
欢迎关注 『youcans 的 OpenCV 例程 200 篇』 系列,持续更新中
欢迎关注 『youcans 的 OpenCV学习课』 系列,持续更新中【youcans 的 OpenCV 例程200篇】01. 图像的读取(cv2.imread)
【youcans 的 OpenCV 例程200篇】02. 图像的保存(cv2.imwrite)
【youcans 的 OpenCV 例程200篇】03. 图像的显示(cv2.imshow)
【youcans 的 OpenCV 例程200篇】04. 用 matplotlib 显示图像(plt.imshow)
【youcans 的 OpenCV 例程200篇】05. 图像的属性(np.shape)
【youcans 的 OpenCV 例程200篇】06. 像素的编辑(img.itemset)
【youcans 的 OpenCV 例程200篇】07. 图像的创建(np.zeros)
【youcans 的 OpenCV 例程200篇】08. 图像的复制(np.copy)
【youcans 的 OpenCV 例程200篇】09. 图像的裁剪(cv2.selectROI)
【youcans 的 OpenCV 例程200篇】10. 图像的拼接(np.hstack)
【youcans 的 OpenCV 例程200篇】11. 图像通道的拆分(cv2.split)
【youcans 的 OpenCV 例程200篇】12. 图像通道的合并(cv2.merge)
【youcans 的 OpenCV 例程200篇】13. 图像的加法运算(cv2.add)
【youcans 的 OpenCV 例程200篇】14. 图像与标量相加(cv2.add)
【youcans 的 OpenCV 例程200篇】15. 图像的加权加法(cv2.addWeight)
【youcans 的 OpenCV 例程200篇】16. 不同尺寸的图像加法
【youcans 的 OpenCV 例程200篇】17. 两张图像的渐变切换
【youcans 的 OpenCV 例程200篇】18. 图像的掩模加法
【youcans 的 OpenCV 例程200篇】19. 图像的圆形遮罩
【youcans 的 OpenCV 例程200篇】20. 图像的按位运算
【youcans 的 OpenCV 例程200篇】21. 图像的叠加
【youcans 的 OpenCV 例程200篇】22. 图像添加非中文文字
【youcans 的 OpenCV 例程200篇】23. 图像添加中文文字
【youcans 的 OpenCV 例程200篇】24. 图像的仿射变换
【youcans 的 OpenCV 例程200篇】25. 图像的平移
【youcans 的 OpenCV 例程200篇】26. 图像的旋转(以原点为中心)
【youcans 的 OpenCV 例程200篇】27. 图像的旋转(以任意点为中心)
【youcans 的 OpenCV 例程200篇】28. 图像的旋转(直角旋转)
【youcans 的 OpenCV 例程200篇】29. 图像的翻转(cv2.flip)
【youcans 的 OpenCV 例程200篇】30. 图像的缩放(cv2.resize)
【youcans 的 OpenCV 例程200篇】31. 图像金字塔(cv2.pyrDown)
【youcans 的 OpenCV 例程200篇】32. 图像的扭变(错切)
【youcans 的 OpenCV 例程200篇】33. 图像的复合变换
【youcans 的 OpenCV 例程200篇】34. 图像的投影变换
【youcans 的 OpenCV 例程200篇】35. 图像的投影变换(边界填充)
【youcans 的 OpenCV 例程200篇】36. 直角坐标与极坐标的转换
【youcans 的 OpenCV 例程200篇】37. 图像的灰度化处理和二值化处理
【youcans 的 OpenCV 例程200篇】38. 图像的反色变换(图像反转)
【youcans 的 OpenCV 例程200篇】39. 图像灰度的线性变换
【youcans 的 OpenCV 例程200篇】40. 图像分段线性灰度变换
【youcans 的 OpenCV 例程200篇】41. 图像的灰度变换(灰度级分层)
【youcans 的 OpenCV 例程200篇】42. 图像的灰度变换(比特平面分层)
【youcans 的 OpenCV 例程200篇】43. 图像的灰度变换(对数变换)
【youcans 的 OpenCV 例程200篇】44. 图像的灰度变换(伽马变换)
【youcans 的 OpenCV 例程200篇】45. 图像的灰度直方图
【youcans 的 OpenCV 例程200篇】46. 直方图均衡化
【youcans 的 OpenCV 例程200篇】47. 图像增强—直方图匹配
【youcans 的 OpenCV 例程200篇】48. 图像增强—彩色直方图匹配
【youcans 的 OpenCV 例程200篇】49. 图像增强—局部直方图处理
【youcans 的 OpenCV 例程200篇】50. 图像增强—直方图统计量图像增强
【youcans 的 OpenCV 例程200篇】51. 图像增强—直方图反向追踪
【youcans 的 OpenCV 例程200篇】52. 图像的相关与卷积运算
【youcans 的 OpenCV 例程200篇】53. Scipy 实现图像二维卷积
【youcans 的 OpenCV 例程200篇】54. OpenCV 实现图像二维卷积
【youcans 的 OpenCV 例程200篇】55. 可分离卷积核
【youcans 的 OpenCV 例程200篇】56. 低通盒式滤波器
【youcans 的 OpenCV 例程200篇】57. 低通高斯滤波器
【youcans 的 OpenCV 例程200篇】58. 非线性滤波—中值滤波
【youcans 的 OpenCV 例程200篇】59. 非线性滤波—双边滤波
【youcans 的 OpenCV 例程200篇】60. 非线性滤波—联合双边滤波
【youcans 的 OpenCV 例程200篇】61. 导向滤波(Guided filter)
【youcans 的 OpenCV 例程200篇】62. 图像锐化——钝化掩蔽
【youcans 的 OpenCV 例程200篇】63. 图像锐化——Laplacian 算子
【youcans 的 OpenCV 例程200篇】64. 图像锐化——Sobel 算子
【youcans 的 OpenCV 例程200篇】65. 图像锐化——Scharr 算子
【youcans 的 OpenCV 例程200篇】66. 图像滤波之低通/高通/带阻/带通
【youcans 的 OpenCV 例程200篇】67. 空间域图像增强的综合应用
【youcans 的 OpenCV 例程200篇】68. 空间域图像增强的综合应用
【youcans 的 OpenCV 例程200篇】69. 连续非周期信号的傅立叶系数
【youcans 的 OpenCV 例程200篇】70. 一维连续函数的傅里叶变换
【youcans 的 OpenCV 例程200篇】71. 连续函数的取样
【youcans 的 OpenCV 例程200篇】72. 一维离散傅里叶变换
【youcans 的 OpenCV 例程200篇】73. 二维连续傅里叶变换
【youcans 的 OpenCV 例程200篇】74. 图像的抗混叠
【youcans 的 OpenCV 例程200篇】75. Numpy 实现图像傅里叶变换
【youcans 的 OpenCV 例程200篇】76. OpenCV 实现图像傅里叶变换
【youcans 的 OpenCV 例程200篇】77. OpenCV 实现快速傅里叶变换
【youcans 的 OpenCV 例程200篇】78. 频率域图像滤波基础
【youcans 的 OpenCV 例程200篇】79. 频率域图像滤波的基本步骤
【youcans 的 OpenCV 例程200篇】80. 频率域图像滤波详细步骤
【youcans 的 OpenCV 例程200篇】81. 频率域高斯低通滤波器
【youcans 的 OpenCV 例程200篇】82. 频率域巴特沃斯低通滤波器
【youcans 的 OpenCV 例程200篇】83. 频率域低通滤波:印刷文本字符修复
【youcans 的 OpenCV 例程200篇】84. 由低通滤波器得到高通滤波器
【youcans 的 OpenCV 例程200篇】85. 频率域高通滤波器的应用
【youcans 的 OpenCV 例程200篇】86. 频率域滤波应用:指纹图像处理
【youcans 的 OpenCV 例程200篇】87. 频率域钝化掩蔽
【youcans 的 OpenCV 例程200篇】88. 频率域拉普拉斯高通滤波
【youcans 的 OpenCV 例程200篇】89. 带阻滤波器的传递函数
【youcans 的 OpenCV 例程200篇】90. 频率域陷波滤波器
【youcans 的 OpenCV 例程200篇】91. 高斯噪声、瑞利噪声、爱尔兰噪声
【youcans 的 OpenCV 例程200篇】92. 指数噪声、均匀噪声、椒盐噪声
【youcans 的 OpenCV 例程200篇】93. 噪声模型的直方图
【youcans 的 OpenCV 例程200篇】94. 算术平均滤波器
【youcans 的 OpenCV 例程200篇】95. 几何均值滤波器
【youcans 的 OpenCV 例程200篇】96. 谐波平均滤波器
【youcans 的 OpenCV 例程200篇】97. 反谐波平均滤波器
【youcans 的 OpenCV 例程200篇】98. 统计排序滤波器
【youcans 的 OpenCV 例程200篇】99. 修正阿尔法均值滤波器
【youcans 的 OpenCV 例程200篇】100. 自适应局部降噪滤波器
【youcans 的 OpenCV 例程200篇】101. 自适应中值滤波器
【youcans 的 OpenCV 例程200篇】102. 陷波带阻滤波器的传递函数
【youcans 的 OpenCV 例程200篇】103. 陷波带阻滤波器消除周期噪声干扰
【youcans 的 OpenCV 例程200篇】104. 运动模糊退化模型
【youcans 的 OpenCV 例程200篇】105. 湍流模糊退化模型
【youcans 的 OpenCV 例程200篇】106. 退化图像的逆滤波
【youcans 的 OpenCV 例程200篇】107. 退化图像的维纳滤波
【youcans 的 OpenCV 例程200篇】108. 约束最小二乘方滤波
【youcans 的 OpenCV 例程200篇】109. 几何均值滤波
【youcans 的 OpenCV 例程200篇】110. 投影和雷登变换
【youcans 的 OpenCV 例程200篇】111. 雷登变换反投影重建图像
【youcans 的 OpenCV 例程200篇】112. 滤波反投影重建图像
【youcans 的 OpenCV 例程200篇】113. 形态学操作之腐蚀
【youcans 的 OpenCV 例程200篇】114. 形态学操作之膨胀
【youcans 的 OpenCV 例程200篇】115. 形态学操作之开运算
【youcans 的 OpenCV 例程200篇】116. 形态学操作之闭运算
【youcans 的 OpenCV 例程200篇】117. 形态学操作之顶帽运算
【youcans 的 OpenCV 例程200篇】118. 形态学操作之底帽运算
【youcans 的 OpenCV 例程200篇】119. 图像的形态学梯度
【youcans 的 OpenCV 例程200篇】120. 击中-击不中变换
【youcans 的 OpenCV 例程200篇】121. 击中-击不中用于特征识别
【youcans 的 OpenCV 例程200篇】122. 形态算法之边界提取
【youcans 的 OpenCV 例程200篇】123. 形态算法之孔洞填充
【youcans 的 OpenCV 例程200篇】124. 孔洞填充的泛洪算法
【youcans 的 OpenCV 例程200篇】125. 形态算法之提取连通分量
【youcans 的 OpenCV 例程200篇】126. 形态算法之凸壳
【youcans 的 OpenCV 例程200篇】127. 形态算法之细化
【youcans 的 OpenCV 例程200篇】128. 形态算法之骨架 (skimage)
【youcans 的 OpenCV 例程200篇】129. 形态算法之骨架 (重建开运算)
【youcans 的 OpenCV 例程200篇】130. 形态学之提取水平和垂直线
【youcans 的 OpenCV 例程200篇】131. 形态学重建之竖线字符提取
【youcans 的 OpenCV 例程200篇】132. 形态学重建之孔洞填充算法
【youcans 的 OpenCV 例程200篇】133. 形态学重建之边界清除
【youcans 的 OpenCV 例程200篇】134. 形态学重建之细胞计数







的一些总结)











